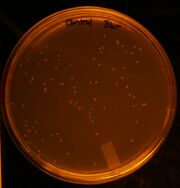
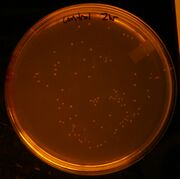
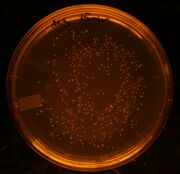
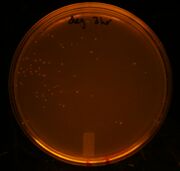

Uploads by Conor McClune
From OpenWetWare
Jump to navigationJump to search
This special page shows all uploaded files.
| Date | Name | Thumbnail | Size | Description |
|---|---|---|---|---|
| 00:39, 14 October 2010 | ConorGel105.jpg (file) |  |
61 KB | |
| 01:31, 24 September 2010 | Assembly 1.JPG (file) |  |
47 KB | |
| 22:19, 21 September 2010 | ConorGel103.jpg (file) |  |
34 KB | |
| 22:13, 21 September 2010 | ConorGel102.jpg (file) |  |
23 KB | |
| 21:58, 18 September 2010 | Conor 9-14-10 2.JPG (file) |  |
29 KB | |
| 23:29, 14 September 2010 | PCR 9-14-10.jpg (file) |  |
18 KB | |
| 23:28, 14 September 2010 | Conor 9-14-10.JPG (file) |  |
37 KB | |
| 01:09, 6 September 2010 | ConorGel100.jpg (file) |  |
62 KB | |
| 22:43, 12 August 2010 | ConorGel99.jpg (file) |  |
31 KB | |
| 22:43, 12 August 2010 | ConorGel98.jpg (file) |  |
27 KB | |
| 00:45, 12 August 2010 | ConorGel97.jpg (file) |  |
34 KB | |
| 23:19, 3 August 2010 | ConorGel96.jpg (file) |  |
51 KB | |
| 00:31, 3 August 2010 | ConorGel95.jpg (file) |  |
68 KB | |
| 00:31, 3 August 2010 | ConorGel94.jpg (file) |  |
66 KB | |
| 03:42, 2 August 2010 | ConorGel92.jpg (file) |  |
49 KB | |
| 02:15, 30 July 2010 | ConorGel91.jpg (file) |  |
514 KB | |
| 01:38, 30 July 2010 | ConorGel90.jpg (file) |  |
142 KB | |
| 20:06, 29 July 2010 | IMG 5640.JPG (file) |  |
54 KB | |
| 20:04, 29 July 2010 | IMG 5473.JPG (file) |  |
611 KB | |
| 19:00, 29 July 2010 | ConorGel89.jpg (file) |  |
46 KB | |
| 18:20, 29 July 2010 | ConorGel88.jpg (file) | |
125 KB | |
| 18:20, 29 July 2010 | ConorGel87.jpg (file) | |
126 KB | |
| 18:20, 29 July 2010 | ConorGel86.jpg (file) |  |
125 KB | |
| 18:18, 29 July 2010 | ConorGel85.jpg (file) |  |
151 KB | |
| 18:17, 29 July 2010 | ConorGel77.jpg (file) | |
144 KB | |
| 18:17, 29 July 2010 | ConorGel78.jpg (file) |  |
155 KB | |
| 18:17, 29 July 2010 | ConorGel79.jpg (file) |  |
152 KB | |
| 18:16, 29 July 2010 | ConorGel80.jpg (file) |  |
154 KB | |
| 18:16, 29 July 2010 | ConorGel81.jpg (file) |  |
148 KB | |
| 18:16, 29 July 2010 | ConorGel82.jpg (file) |  |
119 KB | |
| 18:15, 29 July 2010 | ConorGel83.jpg (file) |  |
135 KB | |
| 18:15, 29 July 2010 | ConorGel84.jpg (file) | |
109 KB | |
| 02:50, 29 July 2010 | ConorGel76.jpg (file) |  |
48 KB | |
| 20:58, 28 July 2010 | ConorGel75.jpg (file) |  |
29 KB | |
| 00:00, 28 July 2010 | ConorGel74.jpg (file) |  |
50 KB | |
| 23:52, 27 July 2010 | ConorGel73.jpg (file) |  |
87 KB | |
| 23:51, 27 July 2010 | ConorGel72.jpg (file) |  |
51 KB | |
| 23:29, 26 July 2010 | ConorGel71.jpg (file) |  |
61 KB | |
| 20:40, 26 July 2010 | IMG 5559.JPG (file) |  |
28 KB | |
| 20:39, 26 July 2010 | IMG 5561.JPG (file) |  |
31 KB | |
| 20:12, 26 July 2010 | ConorGel70.jpg (file) |  |
45 KB | |
| 17:54, 26 July 2010 | ConorGel69.jpg (file) |  |
61 KB | |
| 00:13, 24 July 2010 | ConorGel68.jpg (file) |  |
45 KB | |
| 23:19, 23 July 2010 | ConorGel67.jpg (file) |  |
596 KB | |
| 23:18, 23 July 2010 | ConorGel66.jpg (file) |  |
38 KB | |
| 21:34, 23 July 2010 | ConorGel65.jpg (file) |  |
524 KB | |
| 00:34, 23 July 2010 | ConorGel64.jpg (file) |  |
108 KB | |
| 21:51, 22 July 2010 | ConorGel63.jpg (file) |  |
60 KB | |
| 16:57, 21 July 2010 | ConorGel61.jpg (file) |  |
43 KB | |
| 00:14, 21 July 2010 | ConorGel60.jpg (file) |  |
33 KB |